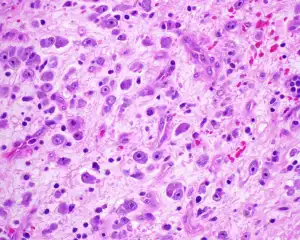
blog-300-240 blog-300-240

How does centella asiatica aid in wound healing and skin repair?
Centella asiatica, also known as gotu kola, is a herb that has been used for centuries in traditional medicine systems for its remarkable wound healing and skin repair properties. Modern research has validated many of the traditional uses of this powerful plant, particularly when it comes to supporting skin health. In this article, we'll explore how centella asiatica extract powder aids in wound healing and skin repair, examining its key benefits and mechanisms of action.

English name: Gotu Kola Extract
Latin Name:Centella Asiatica(L.) Urban
Active ingredients: asiaticoside
Specification: 10%-90%
CAS No.: 16830-15-2
Molecular forula: C48H78O19
Molecular Weight: 959.12
Use Part : The whole herb
Appearance: Brown-yellow to White Powder
Mesh size:80 Mesh
Test Method: HPLC
Skin benefits of centella asiatica extract powder
Centella asiatica extract powder offers a wide range of benefits for skin health and repair:
Accelerates wound healing
One of the most well-documented benefits of centella asiatica extract powder is its ability to accelerate wound healing. The active compounds in centella asiatica, particularly asiaticoside, madecassoside, and asiatic acid, work synergistically to promote faster wound closure and regeneration of damaged skin tissue. Studies have shown that centella asiatica extract powder can significantly reduce wound healing time compared to untreated wounds.

Reduces inflammation
Centella asiatica extract powder possesses potent anti-inflammatory properties that help soothe irritated skin and reduce redness. This makes it beneficial for inflammatory skin conditions like eczema, psoriasis, and acne. By calming inflammation, centella asiatica extract powder creates an optimal environment for skin repair and regeneration.

Improves skin hydration
The triterpenoid compounds in centella asiatica extract powder help boost skin hydration by enhancing the skin's natural moisturizing factors. Well-hydrated skin is more resilient and better able to repair itself. The moisturizing effects of centella asiatica extract powder make it particularly useful for dry, dehydrated skin types.

Enhances skin barrier function
Centella asiatica extract powder helps strengthen and repair the skin's protective barrier. A healthy skin barrier is crucial for preventing moisture loss and protecting against environmental stressors. By supporting barrier function, centella asiatica extract powder helps skin maintain optimal hydration levels and defend against irritants.

Provides antioxidant protection
The phenolic compounds in centella asiatica extract powder act as powerful antioxidants, neutralizing free radicals that can damage skin cells. This antioxidant activity helps protect the skin from oxidative stress and premature aging. Regular use of centella asiatica extract powder can help maintain skin's youthful appearance and resilience.
How centella asiatica promotes collagen production?
One of the key mechanisms by which centella asiatica extract powder aids in wound healing and skin repair is through its ability to stimulate collagen production:
Increases fibroblast proliferation
Centella asiatica extract powder has been shown to increase the proliferation of fibroblasts, the cells responsible for producing collagen and other extracellular matrix components. By stimulating fibroblast activity, centella asiatica extract powder helps boost the skin's natural collagen production processes.
Enhances collagen synthesis
The active compounds in centella asiatica extract powder, particularly asiaticoside, directly stimulate collagen synthesis in skin cells. This increased collagen production leads to improved skin elasticity, firmness, and overall structural integrity. Enhanced collagen synthesis is especially beneficial for wound healing and reducing the appearance of scars.
Inhibits collagen breakdown
In addition to promoting collagen synthesis, centella asiatica extract powder also helps prevent the breakdown of existing collagen. It achieves this by inhibiting enzymes that degrade collagen, such as matrix metalloproteinases (MMPs). By preserving collagen, centella asiatica extract powder helps maintain skin's strength and resilience.
Promotes proper collagen organization
Centella asiatica extract powder not only increases collagen production but also supports proper collagen organization and alignment. This is crucial for optimal wound healing and scar prevention. Well-organized collagen fibers result in stronger, more flexible skin with improved texture and appearance.
Supports glycosaminoglycan production
Glycosaminoglycans (GAGs) like hyaluronic acid are essential components of the skin's extracellular matrix that work alongside collagen to maintain skin hydration and structure. Centella asiatica extract powder has been shown to enhance GAG production, further supporting skin repair and hydration.

Uses of centella asiatica in skincare products
The remarkable skin benefits of centella asiatica extract powder have led to its widespread use in various skincare products:
Wound healing ointments and creams
Centella asiatica extract powder is commonly found in wound healing ointments and creams due to its ability to accelerate tissue repair. These products are used to treat minor cuts, scrapes, and burns, promoting faster healing and reducing the risk of scarring.
Anti-aging serums and moisturizers
The collagen-boosting and antioxidant properties of centella asiatica extract powder make it a popular ingredient in anti-aging skincare products. Serums and moisturizers containing centella asiatica can help improve skin elasticity, reduce the appearance of fine lines and wrinkles, and promote a more youthful complexion.

Scar reduction treatments
Centella asiatica extract powder is often included in scar reduction treatments and products designed to improve the appearance of existing scars. Its ability to promote proper collagen organization and enhance skin regeneration makes it effective for minimizing the visibility of scars from acne, surgery, or injuries.
Calming and soothing products
The anti-inflammatory properties of centella asiatica extract powder make it beneficial in products designed to soothe sensitive or irritated skin. It's commonly found in toners, essences, and face masks formulated for calming redness and inflammation.

Sun damage repair products
Centella asiatica extract powder can help repair and protect skin from sun damage. Its antioxidant and regenerative properties make it useful in after-sun products and treatments designed to address photodamage and support skin recovery.
Acne treatments
The wound healing and anti-inflammatory benefits of centella asiatica extract powder can be helpful in managing acne. It's often included in spot treatments and acne-fighting products to help heal blemishes and reduce associated redness and inflammation.

Stretch mark prevention and treatment
Centella asiatica extract powder's ability to support collagen production and skin elasticity makes it beneficial for preventing and improving the appearance of stretch marks. It's commonly found in body creams and oils designed for use during pregnancy or weight fluctuations.
Conclusion
Centella asiatica extract powder is a powerful natural ingredient that offers numerous benefits for wound healing and skin repair. Its ability to accelerate wound closure, stimulate collagen production, reduce inflammation, and provide antioxidant protection makes it a valuable addition to skincare routines and treatments. From promoting faster healing of minor injuries to supporting overall skin health and appearance, centella asiatica extract powder has proven itself to be a versatile and effective skincare ingredient.
As a leading centella asiatica extract powder manufacturer, Shaanxi Rebecca Biotechnology Co., Ltd. is committed to providing high-quality, pure, and potent centella asiatica extract powder for use in various skincare and pharmaceutical applications. Our advanced production processes and strict quality control measures ensure that our centella asiatica extract powder retains its maximum nutritional benefits and bioavailability. To learn more about our centella asiatica extract powder and other natural herbal extracts, please contact us at information@sxrebecca.com.
FAQ
Is centella asiatica extract powder safe for all skin types?
Centella asiatica extract powder is generally well-tolerated by most skin types, including sensitive skin. However, as with any new skincare ingredient, it's always best to perform a patch test before widespread use.
How long does it take to see results from using centella asiatica extract powder?
Results can vary depending on the specific skin concern and product formulation. For wound healing, improvements may be noticeable within a few days to weeks. For anti-aging benefits, consistent use over several weeks to months may be necessary to see significant results.
Can centella asiatica extract powder be used during pregnancy?
While topical use of centella asiatica extract powder is generally considered safe, it's always best to consult with a healthcare provider before using any new skincare products during pregnancy.
References
1. Bylka W, Znajdek-Awiżeń P, Studzińska-Sroka E, Brzezińska M. Centella asiatica in cosmetology. Postepy Dermatol Alergol. 2013;30(1):46-49.
2. Gohil KJ, Patel JA, Gajjar AK. Pharmacological Review on Centella asiatica: A Potential Herbal Cure-all. Indian J Pharm Sci. 2010;72(5):546-556.
3. Ratz-Łyko A, Arct J, Pytkowska K. Moisturizing and antiinflammatory properties of cosmetic formulations containing Centella asiatica extract. Indian J Pharm Sci. 2016;78(1):27-33.
4. Chong NJ, Aziz Z. A Systematic Review of the Efficacy of Centella asiatica for Improvement of the Signs and Symptoms of Chronic Venous Insufficiency. Evid Based Complement Alternat Med. 2013;2013:627182.
5. Sh Ahmed A, Taher M, Mandal UK, et al. Pharmacological properties of Centella asiatica hydrogel in accelerating wound healing in rabbits. BMC Complement Altern Med. 2019;19(1):213.
_1730691017423.webp)



















